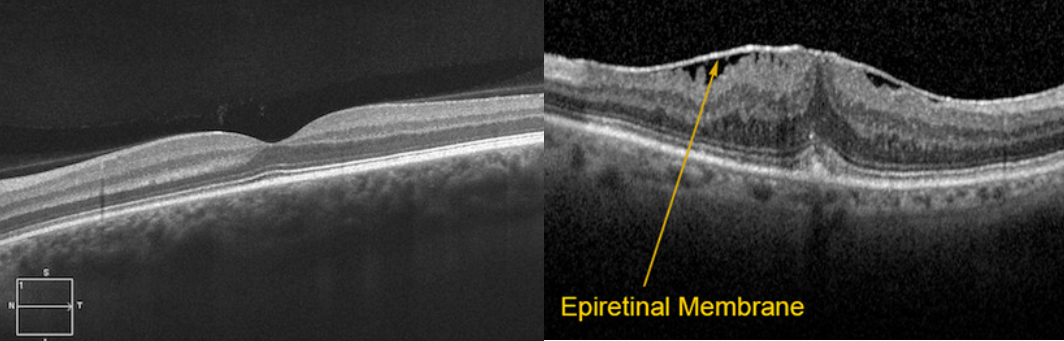

망막앞막은 중심시력을 담당하는 황반이라는 부위의 망막유리체경계면(내경계막)과 유리체 사이에 반투명의 막 조직이 형성되면서 황반의 기능 이상을 일으키는 병입니다. 황반부는 망막앞막이 자주 발생하는 부위이며, 대부분의 망막앞막은 증상이 없거나 경미한 변시증, 중심시력감소를 보입니다.

원인
망막앞막은 50세 이상에서 가장 흔하고 연령 증가에 따라 빈도가 증가한다고 알려져 있으며 여성에서 남성에 비해 더 흔하다고 보고되고 있습니다. 특별한 원인이 되는 안질환이나 병변이 발견되지 않는 특발성이 대부분이며 안과수술, 안염증질환, 망막혈관질환, 안구외상, 안내종양 및 망막변성질환 등과 관련하여 이차적으로 발생할 수 있습니다.
진단
정밀안저검사를 시행하며 빛간섭단층촬영을 통해 황반부의 구조를 자세히 검사하여 진단이 가능합니다. 하지만 집에서도 암슬러 격자를 이용하여 간단히 검사해볼 수 있습니다. 안경 착용자는 안경 착용, 돋보기 착용자는 돋보기 착용 후 한쪽 눈을 가리고 반대편 눈으로 암슬러 격자를 약 30cm 거리에서 암슬러 격자 가운데에 위치한 점에 초점을 맞추고 주시합니다. 반대편 눈도 같은 방법으로 검사합니다. 이 때 시야에 들어오는 모든 선이 수직/수평이어야 하며 모든 사각형이 같아야 합니다. 만약 선이 휘어져 보이거나 선이 끊어져 보이는 등의 이상이 있을 경우 황반변성, 황반원공, 망막앞막, 중심장액맥락망막병증 등의 질환의 가능성이 있으므로 안과에서 정밀검사가 필요합니다.

치료
망막앞막의 두께가 매우 얇거나, 막의 위치가 황반 중심을 벗어나 있는 경우 대부분 증상이 없거나 정상에 가까운 시력을 보입니다. 대다수의 망막앞막은 시간이 지나도 해부학적으로 변하지 않고, 시력도 오랫동안 안정적으로 유지되는 경향이 있습니다. 그러나 망막앞막이 매우 두꺼운 경우, 망막앞막의 견인에 의해 망막두께가 증가하는 경우, 심한 변시증을 호소하거나 시력저하가 심한 경우 등에서 수술적 치료를 고려하게 됩니다.
수술은 유리체절제술을 통해 망막앞막을 제거하고 황반을 견인하는 원인을 없애줘서 망막주름, 황반부종 등을 해결하게 됩니다. 필요에 따라 내경계막 제거술을 같이 시행하기도 합니다.